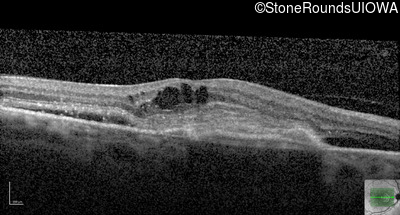
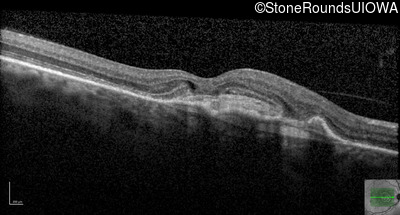
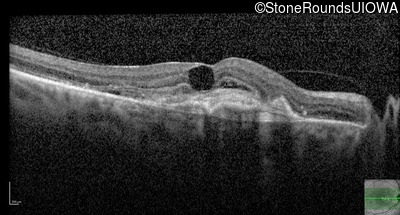
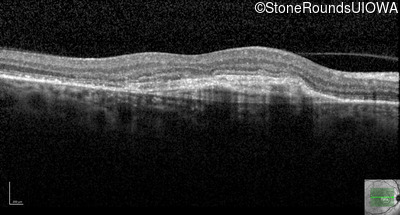
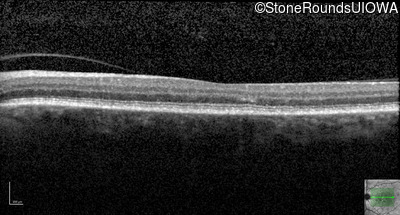
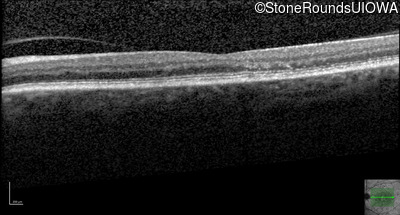
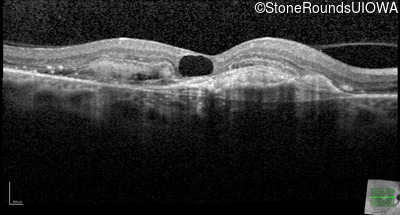
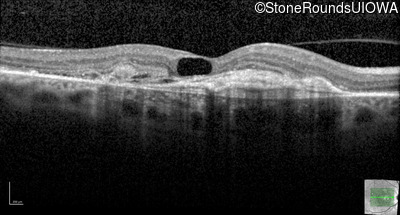
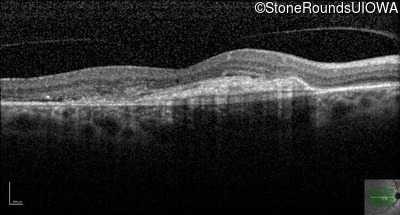
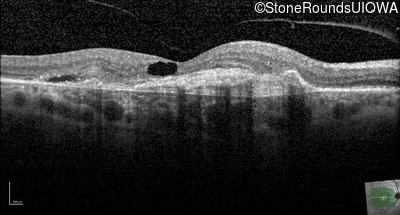
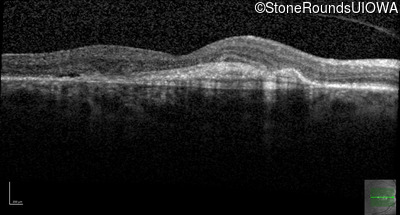
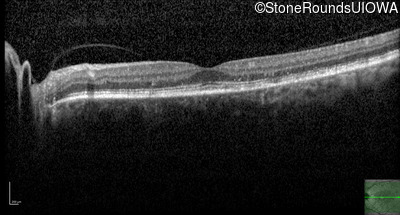
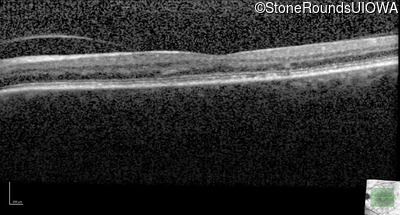
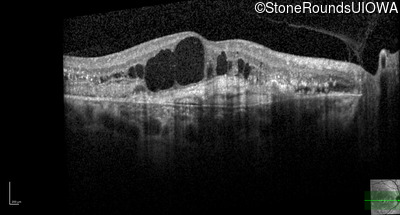
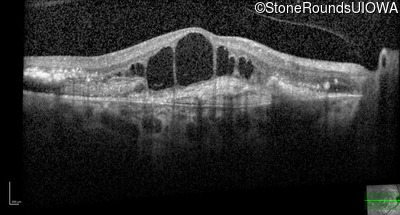
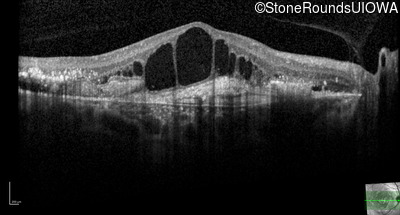
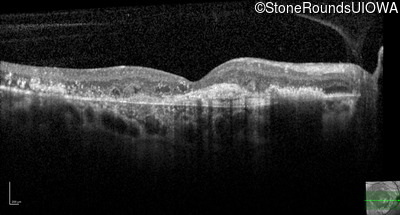
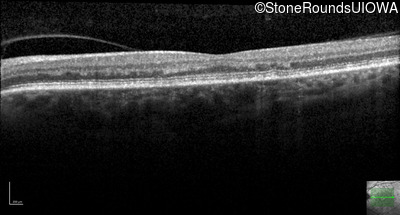
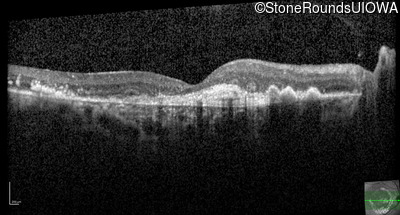
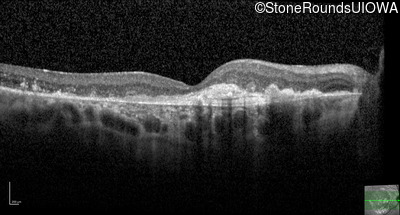

Case
SR2578
Student Mode
AR Stargardt Disease (IIA)
Female
Female
Hidden
SR2578
Student Mode
AR Stargardt Disease (IIA)
Female
Female
History
This 59 year old woman first noticed vision loss in her right eye a few months earlier. She has a cousin with Rhodopsin-associated RP.
| Age at visit: 59 years |
| OD | |||
|---|---|---|---|
| Age at visit: 59 years (Visit 2) |
| OD | OS | ||
|---|---|---|---|
| Age at visit: 59 years (Visit 3) |
| Age at visit: 59 years (Visit 4) |
| OD | |||
|---|---|---|---|
| Age at visit: 59 years (Visit 5) |
| OD | |||
|---|---|---|---|
| Age at visit: 60 years (Visit 2) |
| OD | |||
|---|---|---|---|
| Age at visit: 61 years (Visit 2) |
| OD | |||
|---|---|---|---|
Diagnosis & molecular findings
| Disease | Gene | Allele 1 variant(s) | Allele 2 variant(s) | Inheritance mode |
|---|---|---|---|---|
| AR Stargardt Disease | ABCA4 | Arg219Thr AGA>ACA | Gly863Ala (G)GA>(G)CA | AR |
Disease:
Gene:
Allele 1:
Arg219Thr AGA>ACA
Allele 2:
Gly863Ala (G)GA>(G)CA
Inheritance:
AR